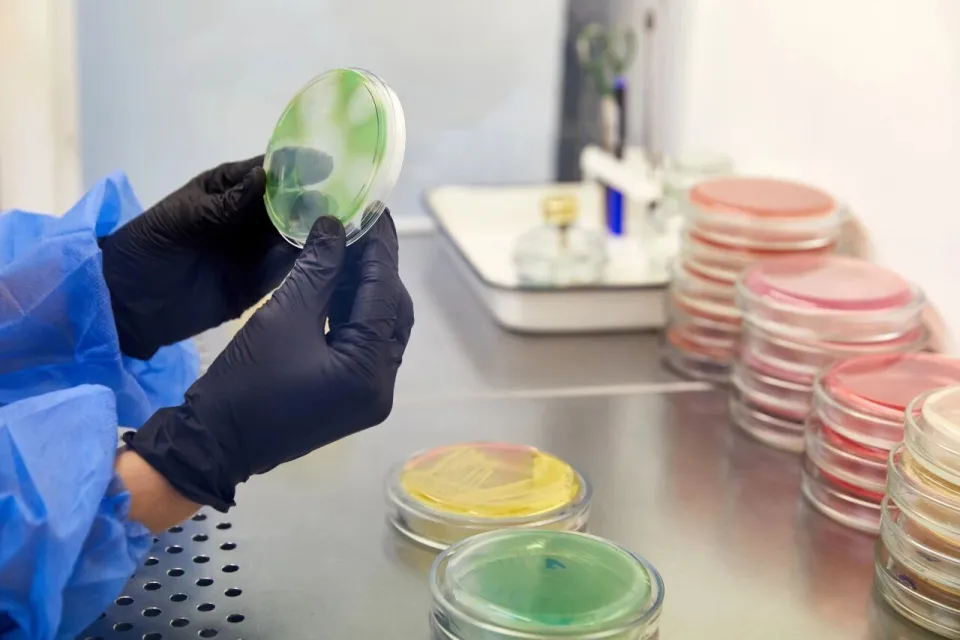
Không chỉ sữa bột, nhiều thực phẩm quen thuộc cũng có thể chứa vi khuẩn Bacillus cereus - thứ khiến Nestlé thu hồi sữa toàn cầu- Ảnh 3.

Điều này diễn ra sau khi Nestlé phát hiện nguyên liệu có nguy cơ nhiễm độc tố gây nôn do Bacillus cereus sinh ra. Chỉ cần nghe đến “độc tố” lại liên quan trực tiếp đến sữa cho trẻ, không ít cha mẹ lập tức hoang mang: vi khuẩn này là gì, nguy hiểm ra sao và làm thế nào để phòng tránh?

Thực tế, Bacillus cereus không phải vi khuẩn hiếm. Nó tồn tại phổ biến trong đất, nước và môi trường tự nhiên . Phần lớn các chủng không gây bệnh cho con người, tuy nhiên một số chủng có độc lực cao lại là mối đe dọa đáng kể đối với an toàn thực phẩm. So với nhiều loại vi khuẩn khác, Bacillus cereus “đáng gờm” hơn vì sở hữu hai đặc điểm sinh tồn khiến cả ngành thực phẩm lẫn người tiêu dùng phải dè chừng.
- Khả năng tạo bào tử cực bền: Là vi khuẩn sinh bào tử, Bacillus cereus có thể tạo ra bào tử ngủ khi điều kiện môi trường bất lợi. Những bào tử này có lớp “áo giáp” dày, giúp chúng chịu được nhiệt độ cao, khô hạn và thiếu dinh dưỡng . Khi môi trường thuận lợi trở lại, bào tử sẽ nảy mầm và tiếp tục sinh sôi.
Chính vì độ “lì đòn” này, đun nấu thông thường trong gia đình không đủ để tiêu diệt bào tử . Trong sản xuất công nghiệp, thường phải dùng phương pháp tiệt trùng hơi nước áp suất cao mới có thể xử lý triệt để. Đây là lý do Bacillus cereus rất khó kiểm soát.
- Khả năng sinh độc tố: Nguy hiểm hơn, một số chủng Bacillus cereus có thể sinh độc tố , gồm độc tố gây nôn và độc tố đường ruột . Trong đó, độc tố gây nôn là loại đáng lo nhất và cũng chính là “nhân vật chính” trong vụ sữa bột bị thu hồi.
Để sinh độc tố gây nôn, vi khuẩn cần hai điều kiện: bản thân chủng vi khuẩn phải có gen sinh độc tố và môi trường thực phẩm phù hợp.

Thực phẩm giàu tinh bột là “mảnh đất màu mỡ” nhất, điển hình là cơm nguội . Không ít vụ ngộ độc thực phẩm từng được ghi nhận sau khi ăn cơm để qua đêm hoặc cơm chiên từ cơm cũ. Thậm chí, có trường hợp ăn cơm để nhiều ngày đã bị sốc, suy đa tạng , nguy hiểm đến tính mạng. Vì vậy, ngộ độc dạng này còn được gọi là “hội chứng cơm chiên” .
Đáng chú ý, độc tố gây nôn rất bền nhiệt . Nghĩa là một khi cơm đã bị nhiễm vi khuẩn và sinh độc tố, việc hâm nóng hay chiên lại cũng không thể loại bỏ độc tố . Khi xâm nhập cơ thể, nhẹ thì gây buồn nôn, nôn ói; nặng có thể dẫn đến suy gan, tổn thương não do gan , thậm chí tử vong.
Bacillus cereus có thể phát triển trong khoảng nhiệt độ từ vài độ C đến 50 độ C, nhưng sinh độc tố mạnh nhất ở 20-37 độ C , đặc biệt lý tưởng là 28-35 độ C . Đây cũng chính là nhiệt độ phòng, nhất là vào mùa hè, lý giải vì sao ngộ độc loại này thường bùng phát khi thời tiết nóng.
Ngoài cơm, mì, bún, miến, khoai tây nghiền, rượu nếp ngọt , cùng các sản phẩm từ sữa cũng là nhóm thực phẩm dễ bị nhiễm Bacillus cereus nếu bảo quản không đúng cách .
Một số chủng khác không sinh độc tố gây nôn mà tạo độc tố đường ruột , gây tiêu chảy và đau bụng. Loại độc tố này kém bền hơn, ít nguy hiểm và thường tự khỏi sau 1-2 ngày. Ngộ độc tiêu chảy do Bacillus cereus thường liên quan đến thịt, hải sản, sữa và rau , phổ biến hơn ở châu Âu và Bắc Mỹ, trong khi dạng gây nôn lại hay gặp ở châu Á, có thể do thói quen ăn uống khác nhau.
Bảo quản đúng cách là chìa khóa phòng ngừa
Trong số các “thủ phạm”, cơm nguội vẫn là mối nguy lớn nhất. Việc nấu dư cơm là điều khó tránh, thậm chí nhiều người còn cố tình nấu nhiều để hôm sau làm cơm chiên. Cơm thừa không đáng sợ, đáng sợ là bảo quản sai cách . Không phải đợi đến khi cơm có mùi ôi hay mốc mới gây hại, bởi độc tố có thể tồn tại trong bát cơm trông vẫn trắng và bình thường .
Cơm ăn không hết cần cho vào hộp sạch, làm nguội nhanh và bảo quản trong ngăn mát tủ lạnh , tốt nhất dùng hết trong ngày hôm sau. Nếu cần để lâu hơn, nên cấp đông . Các thực phẩm giàu tinh bột và sữa cũng cần được xử lý tương tự.
Với doanh nghiệp thực phẩm, do vi khuẩn này tồn tại rộng khắp trong môi trường và có khả năng chịu nhiệt cao, việc kiểm soát nguyên liệu, vệ sinh nhà xưởng và quy trình sản xuất là yếu tố then chốt để tránh rủi ro an toàn thực phẩm.
Một vi khuẩn quen thuộc trong tự nhiên, nhưng chỉ cần một khâu bảo quản lơ là, nó có thể trở thành mối nguy ngay trên chính mâm cơm gia đình.
Nguồn và ảnh: QQ




































Hoặc